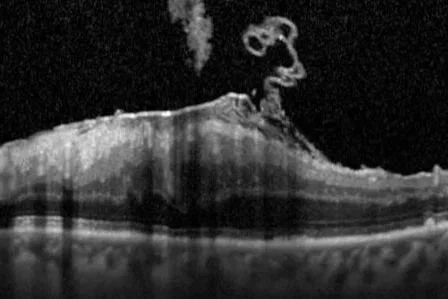

Members of the OIA are encouraged to pursue and continually develop skills and behaviours that ensure clinical environments are effective and safe for patients and healthcare staff.
Ophthalmic and Vision Scientists, of all levels, should follow the values of Good Scientific Practice and the Standards of the Health and Care Professions Council.
Standards of Practice for specific Ophthalmic Imaging techniques will be provided below.
These need to be presented at the OIA Conference in November 2025 for ratification by the membership.
Standards of Ophthalmic Imaging will be routinely reviewed.
Good Scientific Practice 2025
Academy for Healthcare Science: “Good Scientific Practice sets out the values and behaviours expected of all those working in the healthcare science workforce. The standards originally published in 2012, were reviewed and updated in 2021 following an extensive review process. A summary of the changes is available here. These standards are used by education and training providers, learners, and registrants to ensure that safe and good working practice is used throughout the profession. They can also help the public understand what they can expect from the healthcare science workforce.” https://www.ahcs.ac.uk/education-training/standards/
Ophthalmic Science Practitioner
Academy for Healthcare Science: Standards of Proficiency are used to guide the education, training and practice of the healthcare science workforce. As well as acting as a benchmark for AHCS registration. This is the Standard that students at the university of Gloucestershire have to demonstrate to be able to graduate as Ophthalmic Healthcare Science Practitioners
Healthcare Scientists
The Health & Care Professions Council are the regulatory body for Healthcare Scientists, as such their standards describe how professionals should represent themselves and what registrants can expect from education, training and support.
They set the standards for Standards of conduct, performance and ethics. setting our how registrants are expected to behave, and what the public can expect from a healthcare professional.
OIA Standards - Coming Soon
OCT
Coming soon
Slit Lamp
Coming soon
Fundus Photography
Coming Soon
Angiography
Coming soon
External Photography
Coming soon
Biometry
Coming Soon
Ultrasound
Coming soon
Paediatric
Coming soon